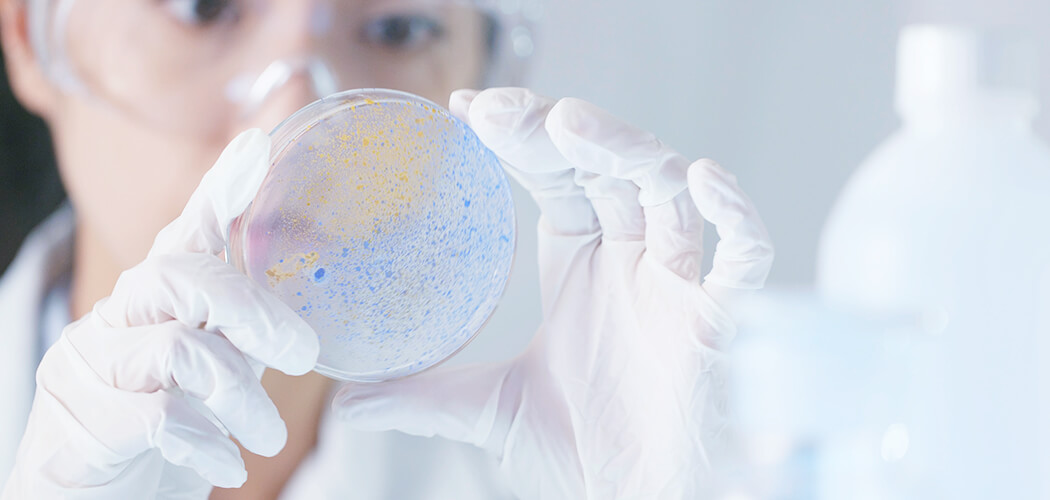
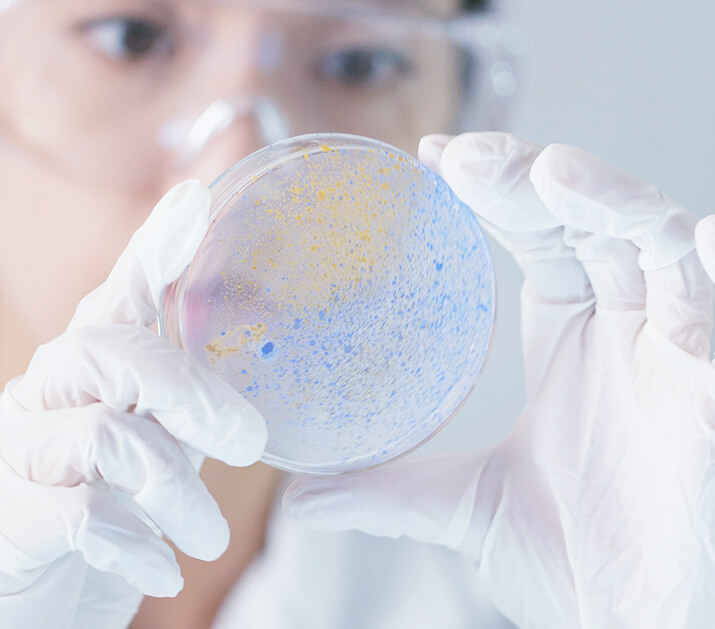
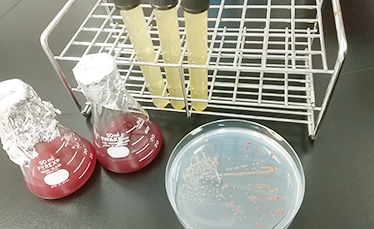
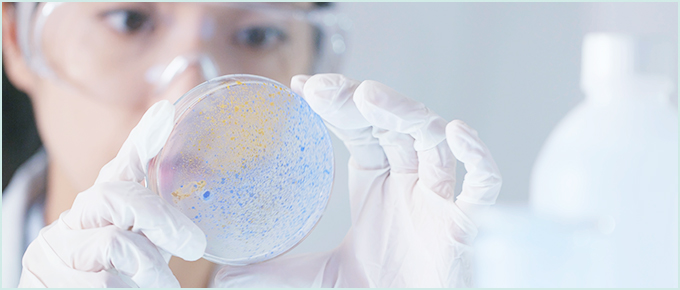

数物科学科
数学と物理学は、論理と思考、自然の法則に根ざした学問です。
数物科学科では数学と物理学の基礎から応用まで
深く学び、双方の知識を連携させることで、論理的思考力と解析力を育成。
複雑な現代の課題を解決する力を養います。
数学コース
あらゆることに数学的問題意識を持ち、その数理モデルを構築し、数学的解析を行う事で、物事の成り立ちや変化の過程を明らかにする学問、それが数学です。
悠久の地奈良で、数学に没頭し、本格的に数学に浸るコースです。
キーワード


- 抽象化と具体化モデル
- 純粋数学
- 現象から理論を展開し普遍的な法則を導く
- 数学は自由な精神から生まれる
- 数学的構造を見抜く目
- 明晰な数学的言語で事象を捉え論証し表現する力
- 分野横断的な授業
- 代数学---抽象化、数学的言語の構築・研究
- 幾何学---幾何的モデルの構築・研究
- 解析学---微積分学を用いた数理モデルの構築・研究


-

01
-

02
-

03
-

04
- 01岡潔図書室にて
勉強中 - 02共同図書館
(高度な専門書) - 03岡潔博士
(本学名誉教授)の
講義ノート - 04子鹿---
詰まった時は
鹿と触れ合って
気分転換
物理学コース
物理学は自然界にかくれた真理を探り、様々な現象を統一的に説明する学問です。宇宙や天体から、原子、さらにはその奥にある素粒子の極微の世界までを対象とする一方で、私達の身の回りにある自然現象、人自身を形作る物質までもが研究されています。複雑に見える自然現象の背景にある普遍的な基本法則を理解することが物理学の目的です。
キーワード


- 自然の法則物質のはじまり
- 質量の起源
- イオンビーム
- 量子メス(イオン加速器の医療応用)
- 虹散乱現象
- ペレトロン加速器
- 暗黒物質、銀河、宇宙の未来は?
- 次世代観測
- ミッション
- 自然が作る形
- カオス
- フラクタル
- 超弦理論
- モンテカルロシミュレーション
- 超伝導
- トポロジカル量子物質


-

01
-

02
-

03
-

04
- 01X線が映し出す
宇宙の壮大な銀河と
銀河の連なり - 02イオンビーム実験に
役立つペレトロン
加速器。医療応用等の礎となる。 - 03高速に加速した
重い原子核を
正面衝突させて
できる何百もの粒子を
PHENIX検出器で
観測した様子 - 04粒子の性質を
高速計算機を用いて
シミュレーションする
格子QCD
シミュレーション
数物連携コース
数物連携コースでは、計算機プログラミングスキルを身につけながら、数学と物理学のバランスの取れた理解を深め、最先端の研究を通して問題解決能力やコミュニケーション力を磨き、社会に貢献できる人材を育成しています。数学と物理学の両方の魅力を探求してみませんか?
キーワード


- 連携
- 数学
- 物理学
- プログラミング
- コミュニケーション能力
- 非平衡ダイナミクス
- ゲーム情報学
- パターン形成
- 結晶の対称性と電子状態
- 折り紙の数学
- ナノ電子系の理論


-

01
-

02
-

03
-

04
- 01研究発表の様子
- 02プログラミング
- 03研究室で保有する
計算機サーバ - 04セミナー風景

化学生物環境学科
化学、生物科学、環境科学の3つのコースに分かれますが、
コースにまたがる科目があったり、
他コースの科目をほぼ自由に受講できるなど、
物質、生命、地球といった多層的な視点から自然を探求していくことができます。
また、入学後の興味の変遷等で、進級時にコースを変わることも容易です。
化学コース
現代の化学は、基礎的な学問の分野が高度化し、多彩な応用的研究が展開され、化学を取り巻く学際領域の多様化、複雑化が急速に進んでいます。化学コースでは、基礎から応用までの系統的な教育カリキュラムを通して、化学の基礎力と実社会で役立つ柔軟な応用力を身につける教育を行っています。
キーワード


- 物理化学
- 分子や分子集合体の性質・構造を電子・原子・分子の視点から解明する
- 有機化学、有機分子を鍵として持続可能な社会を築く
- 機能性有機分子材料を開発する
- 無機化学
- 物質の機能を精密設計する
- 分子レベルから生命の仕組みを解明する
- エネルギー
- 再生可能資源
- 触媒
- 遷移金属錯体
- 分子結晶
- 両親媒性イオン液体
- 分子磁性
- 界面活性剤
- 発光材料
- 核酸
- 水素
- ものづくり
- グラフェン
- コンピュータシミュレーション
- キラリティ
- 酵素
- 波動性
- ラマン分光


-

01
-

02
-

03
-

04
- 01実習で実験の
基礎技術を習得 - 02さまざまな
分析機器を駆使 - 03精製装置を用いた
化合物の単離 - 04新しい発見への期待
生物科学コース
これまで知識として学んできた生物学とはひと味違う、生命に関わる謎の探究を一緒にしませんか。生き物好きで将来は生物に関連する職に就きたい人、普遍的な生命現象に興味を持つ人、生物の多様性に魅せられてその謎を解きたい人、生物科学コースはそのような皆さんをお待ちしています。
キーワード


- 生命の謎に迫る
- 普遍性と多様性
- 生物が好き
- あなたを知る
- 自ら考え、伝え、実践する
- 探究心と好奇心
- 生物の不思議
- 生命科学の階層性


-

01
-

02
-

03
-
04
- 01臨海実習で
自然に触れる - 02植物とハナバチの
相互作用 - 03研究室で保有する
非視覚系で光を
受容する魚たち - 04硫化水素を使って
光合成する細菌
環境科学コース
地球環境をとりまく現象は分子から地球までの空間スケールに至ります。そしてそれらの現象は私たちの日常の時間単位から地球の46億年の歴史的時間へとつながります。環境科学コースでは、これらの自然現象を解明すると共に、対策技術の開発を通して、環境対応型社会の構築を目指します。
キーワード


- 衛星から観る地球環境
- 生命の仕組みを数式で考える
- 環境問題に化学の視点から取り組む
- 環境問題への生物的アプローチ
- シミュレーション
- 相互作用
- 地球温暖化・カーボンニュートラル
- 化学汚染
- 保全


-

01
-

02
-

03
-

04
- 01新入生歓迎会
- 02数理モデル
演習の様子 - 03ドローンを用いた
実験の様子 - 04衛星データ解析の
セミナーの様子
進路
卒業生の歩み
卒業生たちは様々な分野で、多様な仕事をしています。
どんな仕事をしているのか、奈良女子大学理学部での経験がどのように活かされているか、教えてもらいました。
-

小倉理愛さん

小倉理愛さん
- 数物科学科
数物連携コース
2018年卒業 - 大学院博士前期課程
数物科学専攻
数学コース
2020年修了
東芝情報システム株式会社
LSIソリューション事業部 ソリューション第五部 勤務数物科学科卒業
数物科学科卒業
私は現在、メモリの評価解析を担当しています。量産用テストのプログラム作成が主な業務です。
大学に入学した年がちょうど数物科学科ができた年で、両方を学べる連携コースを選択しました。当初は教員になる想定でいたため、中学と高校の数学理科の教員免許を取得しました。学生は真面目な人達が多く、先生方は親身で質問もしやすい、学びやすい環境でした。
演習やゼミでの、自分で黒板に書いた内容を人前で解説する、他の学生の説明を聞く、先生方や学生から不備を指摘され更に考え直す、などの繰り返しから、いつの間にか論理的に考える力が育まれていったように思います。
現在の仕事は大学で学んだ内容に直接関係はありませんが、学び続けることへの忌避感のなさ、論理的な思考が評価され、採用に繋がったように感じています。
将来何になりたいかで学問を選ぶ方法もありますが、私個人としては、興味があるもの、面白いと思う学問を選択することをおすすめします。
- 数物科学科
数物連携コース
2018年卒業 - 大学院博士前期課程
数物科学専攻
数学コース
2020年修了
東芝情報システム株式会社
LSIソリューション事業部 ソリューション第五部 勤務数物科学科卒業
数物科学科卒業
- 数物科学科
-

佐々木智子さん

佐々木智子さん
- 数物科学科
物理学コース
2019年卒業 - 大学院博士前期課程
数物科学専攻
物理学コース
2021年修了
サンディスク合同会社 勤務
数物科学科卒業
数物科学科卒業
私は、自然現象を理解することにとても興味があり、学生時代は物理学を専攻していました。物理学コースではミクロな世界からマクロな世界まで、理論的にも実験的にも、自然現象を学ぶことができます。幅広く講義を受ける中で素粒子理論に興味を持ち、大学院では素粒子理論を研究していました。奈良女子大学は教員のみなさんと会話をする機会がとても多いため、課題への理解を深められるのはもちろんのこと、未知の問題に対する研究者の考え方も学ぶことができます。
私は今、半導体の開発業務に携わっており、日々実験や考察、理論計算を行っています。大学院で研究をしていた素粒子理論と半導体開発は一見、全く異なる分野のように思えます。実際、直接的に使える知識はそう多くはないかもしれません。しかし、学生時代に得た物理学に関する基礎的な知識や、現象を理論的に理解しようとする力は、今でも有益なものになっています。受験生の皆さん、多様な学問領域に卓越した教育と研究が行われている奈良女子大学で、あなたの最大限の可能性を引き出してみませんか。
- 数物科学科
物理学コース
2019年卒業 - 大学院博士前期課程
数物科学専攻
物理学コース
2021年修了
サンディスク合同会社 勤務
数物科学科卒業
数物科学科卒業
- 数物科学科
-

矢田詩歩さん

矢田詩歩さん
- 化学科
(現 化学生物環境学科化学コース)
2014年卒業 - 大学院博士前期課程
化学専攻
(現 化学生物環境学専攻化学コース)
2016年修了 - 大学院博士後期課程
(旧)共生自然科学専攻
2019年修了
東京理科大学工学部工業化学科 勤務
化学科卒業
化学科卒業
私は、博士後期課程を修了後、本学理学部化学生物環境学科化学コースの助教を経て、2023年より東京理科大学工学部工業化学科の助教として勤務しております。
奈良女子大学は、少人数教育であるため、先生方との距離が近く、丁寧な指導を受けることができます。このような恵まれた環境の中で、私自身、学業に専念することができました。学部4年生からは物理化学分野の研究室に所属し、洗剤や化粧品などに使用される界面活性剤を用いたコロイド・界面化学に関する研究を行ってきました。取り組んだ研究は大変面白く、研究を通して社会の役に立ちたいと考えるようになり、本学の大学院に進学しました。現在も、大学教員として学生さんたちとともに研究を続けています。
振り返ってみると、学生時代は自分の興味のあることに、がむしゃらに取り組むことができた貴重な時間だったと思います。受験生のみなさんには、将来の多くの選択肢が溢れています。化学コースでの学びを通して、将来の夢を見つけませんか?
- 化学科
(現 化学生物環境学科化学コース)
2014年卒業 - 大学院博士前期課程
化学専攻
(現 化学生物環境学専攻化学コース)
2016年修了 - 大学院博士後期課程
(旧)共生自然科学専攻
2019年修了
東京理科大学工学部工業化学科 勤務
化学科卒業
化学科卒業
- 化学科
-

上原澪來さん

上原澪來さん
- 化学生物環境学科
生物科学コース
2018年卒業 - 大学院博士前期課程
化学生物環境学専攻
生物科学コース
2020年修了
日清食品ホールディングス株式会社 勤務
化学生物
環境学科卒業化学生物
環境学科卒業私は大学時代、生物科学を専攻していました。学部では、身近な自然科学を分子・細胞から生態系レベルまで幅広く学び、修士前期課程において専攻した微生物学の知識は今の仕事にも活きています。また、学習内容に加え、合同ゼミや日々の研究を通して得た説明力や計画力、推進力といった基礎能力も、社会人としての土台になっています。
日清食品での主な業務は新商品開発であり、現在は東アジア地区の開発を担う海外駐在員として勤務しています。大学時代に参加したレスター大学との学生交流を通じ、海外の方々と関わる楽しさに気づき、今のキャリアの原点となりました。
大学時代の専攻、研究内容が100%仕事に直結することは少ないかもしれませんが、興味あることに積極的に取り組んだ経験は必ず将来の強みになります。奈良女子大学は温かく、各々の挑戦を後押ししてくれる環境です。ぜひ自分らしく、やりたいことに飛び込んでください!
- 化学生物環境学科
生物科学コース
2018年卒業 - 大学院博士前期課程
化学生物環境学専攻
生物科学コース
2020年修了
日清食品ホールディングス株式会社 勤務
化学生物
環境学科卒業化学生物
環境学科卒業 - 化学生物環境学科
-

若井愛香さん

若井愛香さん
- 化学生命環境学科
(現 化学生物環境学科)
環境科学コース
2018年卒業 - 大学院博士前期課程
化学生物環境学専攻
環境科学コース
2020年修了
ダイキン工業株式会社 勤務
化学生命
環境学科卒業化学生命
環境学科卒業私は、森林が吸収する二酸化炭素量を衛星データから推定する研究をしていました。プログラミングを用いたデータ分析により、誰も知らなかったことを自分の手で解き明かすことにワクワクしながら、日々研究に没頭していました。先生方には、国内外の学会で研究発表をしたり、世界で活躍されている研究者の方々と交流したりする貴重な機会をたくさん頂きました。このような機会を頂いたことで、研究内容に対する理解がより深まったとともに、英語で自信を持ってプレゼンテーションをすることや、海外の方とコミュニケーションを取ることの楽しさを学ぶことができました。
現在は、ダイキン工業で北米事業の企画管理に携わっています。アメリカ・メキシコへ出張し現地の方と一緒に、多種多様なデータの分析結果を基に、将来空調需要が高まる市場に対する事業戦略を考えたり、事業課題に対する取り組みを議論したりしています。学生時代に身に付けたデータ分析のスキル、そして、国内外の学会で発表した経験と、様々な方との交流の経験が、今の私に繋がっています。
- 化学生命環境学科
(現 化学生物環境学科)
環境科学コース
2018年卒業 - 大学院博士前期課程
化学生物環境学専攻
環境科学コース
2020年修了
ダイキン工業株式会社 勤務
化学生命
環境学科卒業化学生命
環境学科卒業 - 化学生命環境学科
取得できる資格、教員免許状
| 数物科学科 | 化学生物環境学科 | |
|---|---|---|
| 取得できる 教員免許状 の種類 |
【数学コース】 中学校教諭一種免許状(数学) 高等学校教諭一種免許状(数学) 【物理学コース】 中学校教諭一種免許状(理科) 高等学校教諭一種免許状(理科) |
中学校教諭一種免許状(理科) 高等学校教諭一種免許状(理科) |
| 取得できる 資格・ 受験資格 |
【数学コース/物理学コース】 学校図書館司書教諭 学芸員 【数物連携コース】 学芸員 |
学校図書館司書教諭 学芸員 |
主な進路
- 数物科学科
-
2023年度
- 【企業】
のぞみ総合法律事務所/NTTドコモ/SOLIZE/アデランス/アンズコーポレーション/市田/オプテージ/オリンパス/クボタ/東京精密/豊田自動織機/トヨタホーム/トヨタ自動車/ニッセイ情報テクノロジー/ピーアイシステム/三菱UFJ銀行/ローム/住友電気工業/川崎重工業/日本総合研究所/日立国際電気 - 【教員】
大阪府(中学校)/門真市(中学校)/帝塚山中学校・高等学校 - 【公務員等】
生駒市/大阪府庁/大阪管区気象台 - 【大学院進学】
奈良女子大学大学院/大阪大学大学院/お茶の水女子大学大学院/九州大学大学院/京都大学大学院/千葉大学大学院/東京大学大学院/東北大学大学院/名古屋大学大学院/神戸大学大学院
- 【企業】
-
2022年度
- 【企業】
FWD生命保険/JALスカイ/NTTドコモ/アクセンチュア/エスユーエス/メイテック/臨海/横河ソリューションサービス/三菱電機/信興テクノミスト/島津ビジネスシステムズ/北陸コンピュータ・サービス/北陸電力/野村総合研究所/両備システムズ - 【教員】
鳥取市(中学校)/兵庫県(高等学校) - 【公務員等】
警察庁近畿管区警察局/奈良県庁/富山県庁 - 【大学院進学】
奈良女子大学大学院/奈良先端科学技術大学院大学
- 【企業】
- 化学生物環境学科
-
2023年度
- 【企業】
JSOL/KSK/TIS/アクセンチュア/アピステ/出光興産/オイシス/大阪弁護士会/オリックス・システム/クボタエイトサービス/志摩スペイン村/ダイキン工業/ノバシステム/浜松ホトニクス/日立製作所/関西電力/阪急阪神百貨店/山本光学/草津電機/大同生命保険/不二新製作所 - 【教員】
大阪府(中学校)/門真市(中学校)/帝塚山中学校・高等学校 - 【公務員等】
大阪市/気象庁 - 【大学院進学】
奈良女子大学大学院/大阪大学大学院/お茶の水女子大学大学院/九州大学大学院/京都大学大学院/千葉大学大学院/東京大学大学院/東北大学大学院/名古屋大学大学院/神戸大学大学院
- 【企業】
-
2022年度
- 【企業】
JALインフォテック/アコム/オプテージ/キューブシステム/クボタ/呉竹/シティ・コム/情報セキュリティ/ダイハツ工業/帝国データバンク/テクノプロ/トランスコスモス/ニッセイ情報テクノロジー/ビッグツリーテクノロジー&コンサルティング/柏ビーズ/楽天カード/ラネット/佐藤薬品工業/上野キヤノンマテリアル/西日本電信電話/大京システム開発/大同工業/日産自動車 - 【公務員等】
鳥取県警察 科学捜査研究所/京都府庁/大阪府庁/京都大学 - 【大学院進学】
奈良女子大学大学院/大阪大学大学院/京都大学大学院/筑波大学大学院/東京大学大学院/東北大学大学院/名古屋大学大学院
- 【企業】
入試概要
-
総合型選抜 探究力入試「Q」
自ら問いを立て、それを解き明かすことが好きな方で、合格した場合は本学への入学を確約できる方に向けた入試です。書類選考による第1次選考と、第1次選考合格者に対して行う第2次選考で選抜します。大学入学共通テストは合否判定に用いませんが、入学前教育の一環として受験していただきます。求める学生像や選抜方法などの詳細は下記サイトをご覧ください。
-
学校推薦型選抜
志望する学科やコースの専門分野に熱意があり、合格した場合は本学への入学を確約できる方に向けた入試です。出身学校長の推薦が必要です。出願時の書類と大学入学共通テストを総合して合否判定を行います。詳細は入試・入学情報をご確認ください。
-
一般選抜
大学入学共通テスト(1月)と、前期日程(2月下旬)または後期日程(3月上旬)の個別学力検査の受験が必要です。大学入学共通テストと個別学力検査の結果を総合して合否判定を行います。詳細は入試・入学情報をご確認ください。
- 入試に関するお問い合わせ
- 奈良女子大学 入試課TEL : 0742-20-3353
合格への道
受験に向けてどんな準備をしたのか、
理学部の先輩たちに聞きました。
一般選抜 前期日程
-
受験時の入試区分、出身県、出身高校、学科(コース)を教えて下さい。
入試区分 一般選抜 前期日程 出身県 愛知県 出身高校 愛知県立豊橋東高等学校 学科・コース 化学生物環境学科 生物科学コース -
高1から高3にかけての受験に向けた準備の様子を、時系列で教えて下さい。
高校1年生 学校の定期テストに向けた勉強を中心に行いました。 高校2年生 1年生に引き続き、学校の定期テストに向けた勉強を中心に行いました。
また、模試の結果を受け、苦手科目の復習を行いました。高校3年生 4月 ~ 5月 2年生3月から新型コロナウイルスの影響で休校となり、自宅で2年生までの復習や苦手科目の復習を行いました。 6月 ~ 8月 新型コロナウイルスの影響で夏休みまで3年生の学習範囲を勉強し、並行して苦手科目の復習を行いました。 9月 ~ 11月 共通テストと二次試験の演習を行いました。 12月 ~ 1月 共通テストの予想問題を中心に解きました。 1月 ~ 2月 私立と国公立の過去問を解き、二次試験の対策を行いました。 -
志望大学・学部と入試区分を最終的に決めたのはいつでしたか?その際の決め手は何でしたか?
私が志望大学を最終的に決めたのは高校3年生の冬、共通テストの後です。大学では生物学を学びたいと思っていて、奈良女では分子から生態系まで幅広く生物について学べ、生徒数が少ないことから手厚い指導が受けられると考え、偏差値など加味して決めました。
-
大学選びや入試区分選びでは何を参考にしましたか。(奈良女のオープンキャンパスに参加された方は、良かったところや大学・学部・入試区分選びに役立ったことがあれば教えてください。)
オープンキャンパスには参加していません。
大学のホームページや予備校のホームページなどを参考に、研究室の研究内容やカリキュラム、偏差値や入試科目などを意識して選びました。
閉じる
一般選抜 後期日程
-
受験時の入試区分、出身県、出身高校、学科(コース)を教えて下さい。
入試区分 一般選抜 後期日程 出身県 愛知県 出身高校 名古屋市立菊里高等学校 学科・コース 数物科学科 -
高1から高3にかけての受験に向けた準備の様子を、時系列で教えて下さい。
高校1年生 学校の定期テストに向けた勉強を中心に行っていました。 高校2年生 高校1年生に引き続き、学校の定期テストに向けた勉強を中心に行いました。また、英単語や数学の苦手分野など、力がつくまでに時間がかかって短期間では出来ないような勉強をするようにしました。 高校3年生 4月 ~ 5月 塾の講座を進めて、授業は内容を定着させるために使いました。英単語は毎日やるようにしていました。 6月 ~ 8月 理系科目は応用を急ぐより苦手分野をなくすための勉強をしました。 9月 ~ 11月 2次試験の過去問を中心に勉強しました。平行して共通テストの予想問題にも取り組んでいました。 12月 ~ 1月 12月は社会科目に力を入れました。また、共通テストの予想問題を解いて復習することを繰り返しました。英語のリーディングは予想問題を毎日やってタイムトレーニングをして、リスニングも毎日30分やっていました。 1月 ~ 2月 2次試験の過去問を解いて、復習することを繰り返しました。 -
志望大学・学部と入試区分を最終的に決めたのはいつでしたか?その際の決め手は何でしたか?
前期の志望大学・学部を決めたのは高2の春でした。後期は共通テストを受けてから改めて考えたので、高3の2月に奈良女子大学に決めました。大学では物理を勉強したいと思っていたのと、将来教員になることも考えていたため、教員免許を取得できること、他の大学では少数になりがちな物理を専攻する女子がたくさん集まる女子大であることなどが奈良女を選んだ決め手となりました。
-
大学選びや入試区分選びでは何を参考にしましたか。(奈良女のオープンキャンパスに参加された方は、良かったところや大学・学部・入試区分選びに役立ったことがあれば教えてください。)
大学のホームページと高校や塾の先生からの話を参考にしました。高校や塾の先生とのお話は、様々な選択肢を知れるだけでなく、大学を決める際のいろんな視点を与えてくださり、とても参考になりました。
閉じる
一般選抜 後期日程
-
受験時の入試区分、出身県、出身高校、学科(コース)を教えて下さい。
入試区分 一般選抜 後期日程 出身県 京都府 出身高校 京都市立堀川高等学校 学科・コース 化学生物環境学科 化学コース -
高1から高3にかけての受験に向けた準備の様子を、時系列で教えて下さい。
高校1年生 高校の授業と定期テストや日々の小テスト、学外模試などの対策と復習を中心に行っていました。理系科目は自分の言葉で理解することを、文系科目は授業で極力吸収することを意識していました。自分が間違えたところを単語帳にまとめ、常に持ち歩いていました。 高校2年生 基本的には高一と変わらないスタイルでしたが、部活動や堀川高校が力を入れていた探究活動にかける時間が増えました。探究活動は秋に集大成を迎えるので、それ以降冬くらいからは少しずつ受験生の意識も高まってきたと思います。 高校3年生 4月 ~ 6月 コロナ禍で在宅学習を強いられましたが、メールツールを用いて先生からの問題や授業動画の配信があったため、それらを軸に進めていました。自分にあったペースで進められた上、これまでを振り返る良い機会になり、私にとってはプラスの時期となりました。 7月 ~ 9月 理系科目は、旧帝大の過去問や実戦模試・オープン模試を積極的に解いていました。部活引退により勉強に注げる時間も増えた一方、解く問題の難化に従って復習や理解に時間がかかり、焦りもありました。基礎に立ちかえることも多かったです。国語と地理は黒本を、英語は長文読解や英作文をメインに行なっていました。 10月 ~ 12月 受験前最後の学校行事であった文化祭後、学校全体として一気に受験モードに切り替わりました。もともと分からないところを友達同士で議論したり教え合う文化はありましたが、より一層その空気間が強まったと感じます。変わらず様々な大学の過去問をメインに進めていました。12月は、各科目全体の9割ほどの時間を共通テスト対策に使っていました。 1月 ~ 3月 共通テスト後、願書を提出してからは受験大学の過去問をひたすら解いていました。前期試験後は、奈良女の過去問を20年分くらいは解いていたと思います。 -
志望大学・学部と入試区分を最終的に決めたのはいつでしたか?その際の決め手は何でしたか?
高3の夏にはある程度心の中では決めていましたが、最終決定は共通テスト後の自己採点分布を見てからです。自分が学びたいことがあること、大学の落ち着いた雰囲気、自宅からの距離などが決め手となりました。
-
大学選びや入試区分選びでは何を参考にしましたか。(奈良女のオープンキャンパスに参加された方は、良かったところや大学・学部・入試区分選びに役立ったことがあれば教えてください。)
オープンキャンパスには高一のときに一度参加しましたが、そのときは食物や栄養学などに興味があったため違う学部を見にいきました。大学の雰囲気は割とどの学部でも似ているので、そのときに感じた印象は大学選びに役立ったと感じます。学生の方から生の話を聞けたことは、大学生活のイメージが湧いてよかったです。それ以外には、高校にいらっしゃった奈良女子大卒の先生の言葉や、大学案内パンフレット、大学HPを参考にしました。
閉じる
学校推薦型選抜
-
受験時の入試区分、出身県、出身高校、学科(コース)を教えて下さい。
入試区分 学校推薦型選抜 出身県 大阪府 出身高校 大阪府立夕陽丘高等学校 学科・コース 数物科学科 -
高1から高3にかけての受験に向けた準備の様子を、時系列で教えて下さい。
高校1年生 興味のある分野を見つけるために、本を読む、大学のパンフレットを取り寄せるなどしました。 高校2年生 塾に通い始め、土日も自習室で勉強をしていました。また、進路相談などでなんとなく志望校を絞り込んでいきました。特に数学について、授業よりも早く自分で予習を進めるようになりました。 高校3年生 共通テストまで 長期休みは塾と学校の講習を受けて、さらに自習室で勉強をしていました。解く問題集をひとつかふたつに絞り、完璧にできるようになることを目標に解いていました。隙間時間に、スマホアプリやYouTubeなどで暗記科目を勉強していました。志望校・受験方式が決まってからは、自己推薦書を書くために、本を読んだり先生方に数学について質問をしたりしていました。 共通テスト後 共通テスト後:国立の2次試験に向けて、過去問や2次対策の問題集を解いていました。 -
志望大学・学部と入試区分を最終的に決めたのはいつでしたか?その際の決め手は何でしたか?
高校3年生の9月ごろに決めました。諸事情で、国公立大学のみの進学を検討していたところ、奈良女子大学の数学科出身の先生に紹介していただき、進路を決めました。自分の学力に合っていたこと、家から通えること、女子大で数学を学べることが決め手となりました。
-
大学選びや入試区分選びでは何を参考にしましたか。(奈良女のオープンキャンパスに参加された方は、良かったところや大学・学部・入試区分選びに役立ったことがあれば教えてください。)
高校の先生からのアドバイスや、入試情報がまとめられている冊子などを参考にしました。各大学のホームページなども参考にしました。
閉じる
総合型選抜 探究力入試「Q」
-
受験時の入試区分、出身県、出身高校、学科(コース)を教えて下さい。
入試区分 総合型選抜 探究力入試「Q」 出身県 兵庫県 出身高校 兵庫県立鳴尾高等学校 学科・コース 化学生物環境学科 環境科学コース -
高1から高3にかけての受験に向けた準備の様子を、時系列で教えて下さい。
高校1年、2年は高校で与えられた課題についてこつこつと取り組みました。共通テストの1年目の学年なので、共通テストの予想問題などを解くことを高校3年で始めました。
-
志望大学・学部と入試区分を最終的に決めたのはいつでしたか?その際の決め手は何でしたか?
高校1年の頃より奈良女の受験を考えていました。高校2年の時に奈良女子大学でQ入試が実施されることを知り、高校3年の春にQ入試で受験することを決めました。1年目のQ入試だったので、皆初めての受験であることから、可能性を感じました。
研究レポートと志望理由書の作成は高校3年の4~5月頃から準備を始めました。
環境に関する身近なテーマとして、自宅の太陽光パネルについて研究レポートを作成することを決め、提出期限まであまり時間がなかったため、集中して取り組みました。 -
大学選びや入試区分選びでは何を参考にしましたか。(奈良女のオープンキャンパスに参加された方は、良かったところや大学・学部・入試区分選びに役立ったことがあれば教えてください。)
高校2年秋にオープンキャンパスに参加しました。文化祭もいっしょに行っており、文化祭がとても楽しかったです。環境科学コースで実施している分光反射率の実験を見学したり、環境科学コースの先生方と話をすることができ、予想に反して大学の先生がやさしそうだと感じました。大学の雰囲気がよくわかり、大学生活に馴染めそうだと感じました。
閉じる